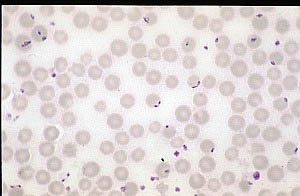

|
Organism: Babesia divergens | |
| Host: Cow | ||
| Preparation: Giemsa's stained blood smear | ||
| Magnification:x1000 |
B.divergens is the "small" Babesia species found in cattle in UK. The parasite is found inside the red cells, usually in pairs at a characteristically wide angle joined at their narrow ends, although other forms might be present.
B.divergens is transmitted by the hard tick Ixodes ricinus and its distribution is thus limited to that of its tick vector. It can be transmitted by each stage of the tick life-cycle but only the female can become infected by feeding on an infected animal.
See also